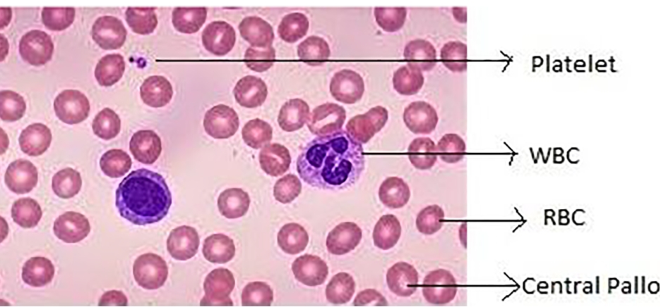
Total Count of RBC, WBC and Platelet

Total Count of RBC, WBC and Platelet 01797522136
Meta Description
Learn about Total Count of RBC, WBC and Platelet including methods, normal ranges, clinical significance, and laboratory procedures. Study pathology and hematology training at HRTD Medical Institute in Dhaka.
Introduction
Blood is one of the most vital components of the human body. It transports oxygen, nutrients, hormones, and immune cells to every part of the body while also removing waste products. Because of this crucial role, analyzing blood components is one of the most common and important laboratory investigations in medical science.

Among various blood tests, the Total Count of Red Blood Cells (RBC), White Blood Cells (WBC), and Platelets is one of the most frequently performed hematology tests. These counts are essential for diagnosing many diseases including anemia, infections, immune disorders, leukemia, bleeding disorders, and bone marrow problems.
For students pursuing careers in medical laboratory technology, understanding these blood tests is extremely important. Practical training in these procedures allows students to develop the necessary skills required in hospitals and diagnostic laboratories.
HRTD Medical Institute, located in Dhaka, Bangladesh, provides professional training in pathology and medical laboratory technology. The institute focuses on both theoretical knowledge and practical laboratory training, enabling students to learn essential diagnostic tests such as RBC count, WBC count, and platelet count.
This comprehensive guide explains the total count of RBC, WBC, and Platelets, their functions, normal values, counting procedures, clinical significance, and how these tests are taught during laboratory training at HRTD Medical Institute.
Total Count of RBC, WBC and Platelet 01797522136
Overview of Blood Components
Blood is a specialized connective tissue composed of cells and plasma. The main components include:
- Red Blood Cells (RBC)
- White Blood Cells (WBC)
- Platelets
- Plasma
Each of these components plays a specific role in maintaining health and protecting the body from diseases.
Total Count of RBC, WBC and Platelet 01797522136
Red Blood Cells (RBC)
Red blood cells are responsible for transporting oxygen from the lungs to body tissues and returning carbon dioxide to the lungs. They contain hemoglobin, a protein that binds oxygen.
Total Count of RBC, WBC and Platelet 01797522136
White Blood Cells (WBC)
White blood cells are part of the immune system and protect the body against infections and foreign substances.
Total Count of RBC, WBC and Platelet 01797522136
Platelets
Platelets are small cell fragments responsible for blood clotting and preventing excessive bleeding.
Understanding the number and function of these cells is essential for diagnosing various medical conditions.

What is the Total RBC Count?
The Total RBC Count measures the number of red blood cells present in a specific volume of blood, usually expressed as cells per microliter.
This test helps evaluate:
- Oxygen-carrying capacity of blood
- Bone marrow function
- Presence of anemia
- Blood disorders
Total Count of RBC, WBC and Platelet 01797522136
Normal RBC Count
Normal RBC levels vary depending on age and gender.
Typical ranges include:
Adult Male
4.7 – 6.1 million cells per microliter
Adult Female
4.2 – 5.4 million cells per microliter
Children
4.0 – 5.2 million cells per microliter
Values outside these ranges may indicate medical conditions that require further investigation.

Functions of Red Blood Cells
Red blood cells perform several critical functions in the human body.
Total Count of RBC, WBC and Platelet 01797522136
Oxygen Transport
The primary function of RBCs is to carry oxygen from the lungs to body tissues. Hemoglobin within RBCs binds oxygen molecules and delivers them to cells.
Carbon Dioxide Transport
RBCs also help transport carbon dioxide from tissues back to the lungs where it is expelled during breathing.
Maintaining Blood pH
Red blood cells contribute to maintaining the acid-base balance of blood.
Total Count of RBC, WBC and Platelet 01797522136
Causes of High RBC Count
An increased RBC count is known as polycythemia. It can occur due to several factors such as:
- Chronic lung disease
- High altitude living
- Dehydration
- Kidney diseases
- Bone marrow disorders
Causes of Low RBC Count
A low RBC count usually indicates anemia and may occur due to:
- Iron deficiency
- Vitamin B12 deficiency
- Blood loss
- Chronic diseases
- Bone marrow problems
Total Count of RBC, WBC and Platelet 01797522136
What is the Total WBC Count?
The Total WBC Count measures the number of white blood cells in a given volume of blood.
White blood cells are essential for the body’s immune defense. They help fight infections caused by bacteria, viruses, fungi, and parasites.
Types of White Blood Cells
There are five major types of white blood cells.
Total Count of RBC, WBC and Platelet 01797522136
1. Neutrophils (40–70%)
Neutrophils are the most abundant type of white blood cell (60–70%) and serve as the immune system’s primary, first-line defense against bacterial and fungal infections. Produced in the bone marrow, these short-lived granulocytes travel to infection sites to kill pathogens via phagocytosis, degranulation, and neutrophil extracellular traps (NETs).
Key Aspects of Neutrophils:
- Function: As innate immune cells, they rapidly respond to infection, injury, or inflammation by destroying microorganisms.
- Life Cycle: They are produced in high numbers (about
per day) in the bone marrow, circulate in the blood, and are typically eliminated by macrophages within a day.
- Immature Forms: Immature neutrophils are called “band cells,” which may be released into the blood when there is high demand, such as a severe infection.
- Normal Levels: A normal neutrophil count is generally between 1,500 and 7,500 cells per microliter of blood.
- Abnormal Levels:
- Neutrophilia: High levels (above 7,500–7,700/µL) indicate infection, inflammation, or physical stress.
- Neutropenia: Low levels (below 1,500/µL) indicate an increased risk of infection
Neutrophils are the most abundant type of WBC. They are the first line of defense against bacterial infections.
Functions:
- Phagocytosis (engulfing and destroying pathogens)
- Release of enzymes to kill bacteria
- Formation of pus during infection
Increased neutrophils (neutrophilia) usually indicate bacterial infection, inflammation, trauma, or leukemia.
Decreased neutrophils (neutropenia) may occur in viral infections, bone marrow disorders, or chemotherapy.
Total Count of RBC, WBC and Platelet 01797522136
2. Lymphocytes (20–40%)
Lymphocytes play a key role in adaptive immunity. They are divided into:
B cells

B cells (B lymphocytes) are a type of white blood cell essential to the adaptive immune system, specifically the humoral immunity component. Originating from hematopoietic stem cells in the bone marrow, they protect the body by producing antibodies—proteins that identify and neutralize invaders like bacteria and viruses. Upon activation, they differentiate into antibody-secreting plasma cells or memory B cells.
Key Aspects of B Cells:
- Function: B cells defend against pathogens by secreting specific antibodies and acting as antigen-presenting cells (APCs). They also release cytokines to regulate immune responses.
- Antibody Production: When activated by an antigen, B cells differentiate into effector cells known as plasma cells, which produce large amounts of antibodies.
- Memory Cells: A portion of B cells become memory B cells, allowing the immune system to recognize and fight previously encountered pathogens faster in the future.
- Development: In mammals, B cells develop and mature in the bone marrow. (The “B” originally stood for the Bursa of Fabricius in chickens, where they were first discovered).
- Subsets: Key subsets include plasma cells (effector cells), memory B cells, and regulatory B cells (Bregs) that manage inflammation.
- Receptors: Unlike other lymphocytes, B cells express B-cell receptors (BCRs) on their surface to
B cells play a crucial role in maintaining immune system balance, and malfunctions in these cells can lead to immune system diseases or malignancies
Total Count of RBC, WBC and Platelet 01797522136
T cells
T cells (T lymphocytes) are critical white blood cells of the adaptive immune system that originate in the bone marrow and mature in the thymus. They identify and destroy infected or cancerous cells and regulate immune responses via two main types

Key Functions and Types of T Cells
- Helper T Cells (CD4+): Act as the “managers” of the immune system by releasing cytokines to activate B cells, cytotoxic T cells, and macrophages.
- Cytotoxic T Cells (CD8+): Directly destroy infected host cells (viruses) and tumor cells using toxic enzymes like perforin and granzyme.
- Regulatory T Cells (Tregs): Suppress immune responses to maintain homeostasis and prevent autoimmunity.
- Memory T Cells: Persist after an infection to provide long-term immunity against previously encountered pathogens.
Origin and Activation
T cells are born in the bone marrow and travel to the thymus to mature. They are activated when their specialized T-cell receptor (TCR) binds to an antigen presented by other cells (e.g., dendritic cells).
Total Count of RBC, WBC and Platelet 01797522136
Natural Killer (NK) cells
Natural Killer (NK) cells are rapid-response lymphocytes of the innate immune system that detect and destroy virus-infected, stressed, or tumor cells without prior activation. As “natural killers,” they patrol the body, distinguishing target cells by detecting reduced MHC class I molecules or increased stress signals. They are critical for tumor surveillance, controlling viral infections, and producing cytokines like IFNγ.
Key Aspects of Natural Killer (NK) Cells:
- Immune Role: As part of the innate immune system, NK cells serve as a first-line, “ready-to-kill” defense. They are crucial for killing virally infected and tumorigenic cells.
- Mechanism of Action: NK cells lyse target cells by releasing cytotoxic molecules like perforin and granzymes, or by triggering death receptors (e.g., TNF receptor ligands).
- Recognition System: Unlike T-cells, which require antigen presentation, NK cells use a balance of activating and inhibitory receptors to recognize cells that are missing “self” markers (MHC class I).
- Origin: They develop from hematopoietic stem cells in the bone marrow, as well as in secondary lymphoid tissues like the spleen and tonsils.
- Classification: While they share common progenitors with T and B cells, they are classified as group I Innate Lymphoid Cells (ILCs).
- Significance in Disease: Reduced NK cell activity or infiltration is associated with tumor progression, while their activation is key for anti-tumor immunity.
Functions:
- Antibody production (B cells)
- Cell-mediated immunity (T cells)
- Destruction of infected or cancerous cells
Lymphocytosis is commonly seen in viral infections such as dengue, hepatitis, and tuberculosis.
Lymphocytopenia may occur in HIV infection, steroid therapy, or immune deficiency disorders.
Total Count of RBC, WBC and Platelet 01797522136
3. Monocytes (2–8%)
Monocytes are the largest type of white blood cell, acting as a crucial component of the innate immune system. Produced in the bone marrow, they circulate in the bloodstream before migrating into tissues to differentiate into macrophages or dendritic cells to fight infections, remove dead cells, and regulate inflammation.
Key Facts About Monocytes:
- Immune Function: They patrol the body for pathogens, using toll-like receptors to detect infections. They are phagocytes, meaning they engulf and destroy bacteria, viruses, and fungi.
- Differentiation: Once they migrate into tissues, they become macrophages (which clear debris and pathogens) or dendritic cells (which present antigens to initiate adaptive immune responses).
- Role in Disease: Monocytes are involved in chronic inflammation, autoimmune diseases, atherosclerosis, and even tumor metastasis.
- Subsets: Human blood contains three main types: classical (phagocytosis), intermediate (inflammatory mediator production), and non-classical (anti-viral response).
- Normal Range: They typically represent about 2–10% of total leukocytes in circulation.
- Monocytosis: An elevated monocyte count (monocytosis) can indicate chronic infection, autoimmune disease, or blood disorders.
Monocytes are the largest WBCs. They transform into macrophages when they enter tissues.
Functions:
- Phagocytosis
- Removal of dead cells
- Chronic inflammation response
Monocytosis may be seen in chronic infections, autoimmune diseases, and certain leukemias.
Total Count of RBC, WBC and Platelet 01797522136
4. Eosinophils (1–4%)
Eosinophils are a type of white blood cell (granulocyte) produced in the bone marrow that play a critical role in the immune system by fighting parasitic infections, regulating allergic reactions, and contributing to inflammation. A normal count is generally under 500 cells/microliter, with elevated levels (eosinophilia) indicating infections, allergies, or autoimmune conditions.
Key Functions and Characteristics
- Immune Defense: They act as a defense against parasitic and fungal infections.
- Allergic Response: They are major players in allergic diseases, asthma, and inflammatory responses.
- Mechanism: When activated, they release toxins from granules to destroy parasites but can also damage host tissues.
Causes of High Eosinophil Levels (Eosinophilia)
A high eosinophil count (>500/

L) often indicates an underlying condition:
- Allergic Disorders: Asthma, eczema, hay fever.
- Infections: Parasitic worms (helminths) and fungal infections.
- Autoimmune Diseases: Certain types of vasculitis or connective tissue diseases.
- Medication Reactions: Drug allergies.
- Bone Marrow Disorders/Cancer: Leukemia or Hodgkin lymphoma. (.gov) +4
Clinical Significance
- Blood Eosinophilia: High levels detected via a Complete Blood Count (CBC).
- Tissue Eosinophilia: High levels in tissues, which may occur even if blood levels are normal.
- Hypereosinophilia: A very high count (
L) sustained over time, which may require medical investigation.
Eosinophils are associated with allergic reactions and parasitic infections.
Functions:
- Combat parasitic infections
- Involvement in asthma and allergies
- Release of inflammatory mediators
Eosinophilia occurs in:
Total Count of RBC, WBC and Platelet 01797522136
Asthma
Asthma is a chronic respiratory condition causing airway inflammation, narrowing, and excess mucus, resulting in symptoms like wheezing, coughing, chest tightness, and shortness of breath. It is caused by a mix of genetic and environmental factors. While it is a lifelong, incurable condition, it is manageable with medication. Common triggers include allergens, cold air, smoke, and exercise.
Key Aspects of Asthma
- Symptoms: Frequent coughing (especially at night), wheezing (high-pitched whistling), shortness of breath, and chest tightness.
- Causes: The exact cause is unknown, but it is believed to be a combination of genetic factors, family history, and environmental triggers.
- Triggers for Attacks: Exposure to irritants such as pollen, dust mites, mold, pet dander, tobacco smoke, cold air, exercise, stress, or respiratory infections (like the flu).
- Duration: Asthma is a long-term, chronic, and incurable disease. While symptoms may go away in some children as they develop, they can return later in life.
- Long-Term Effects: Poorly managed asthma can lead to airway remodeling, where the lungs become permanently scarred, limiting function.
Total Count of RBC, WBC and Platelet 01797522136
Allergic rhinitis
Allergic rhinitis, or hay fever, is an inflammatory immune response to airborne allergens like pollen, dust mites, mold, or pet dander. It causes symptoms such as sneezing, congestion, runny nose, itchy eyes, and throat irritation. Treatment involves antihistamines, nasal corticosteroids, and allergen avoidance.
Symptoms of Allergic Rhinitis
Symptoms often occur immediately after exposure to allergens and can include
- Nasal: Sneezing, nasal congestion (stuffy nose), clear, runny nose (rhinorrhea), and itching in the nose or throat.
- Eyes: Red, itchy, watery, and swollen eyes.
- Other: Fatigue, headache, snoring, clogged ears, or a decreased sense of smell.
- Distinction: Unlike colds, allergic rhinitis rarely causes fever or muscle aches. Wikipedia +3
Causes and Triggers
Allergic rhinitis occurs when the immune system mistakenly identifies harmless substances as harmful, releasing chemicals like histamine. Key triggers include:
- Seasonal Pollen: Trees, grasses, and weeds.
- Indoor Allergens: Dust mites, pet dander, and mold.
- Environmental Factors: Cigarette smoke, pollution, or perfume. (.gov) +4
Treatment Options
- Medications: Oral antihistamines, nasal corticosteroid sprays (most effective), decongestants, and nasal antihistamines.
- Immunotherapy: Allergy shots or sublingual tablets to build tolerance.
- Saline Irrigation: Rinsing nasal passages to wash out allergens.
Risk Factors
- Genetics: A family history of allergies or asthma.
- Atopy: Having other allergic conditions like eczema or asthma.
- Environment: Exposure to indoor allergens or tobacco smoke during early life.
Prevention and Management
While it cannot be cured, you can reduce symptoms by: Asthma and Allergy Foundation of America | AAFA +1
- Keeping windows closed during high pollen seasons.
- Using allergy-proof mattress and pillow covers.
- Showering immediately after being outdoors to wash off pollen.
- Limiting exposure to pets if allergic to dander.
- Using air conditioning with HEPA filters.
Total Count of RBC, WBC and Platelet 01797522136
Parasitic infections
Parasitic infections are diseases caused by organisms—protozoa, helminths (worms), or ectoparasites—that live on or inside a human host to survive, often causing illnesses ranging from mild discomfort to severe, fatal conditions. Spread via contaminated food/water, insects, or poor hygiene, they typically cause digestive issues, fatigue, and rashes, treated with targeted medication.
Common Symptoms of Parasitic Infection
Symptoms vary based on the parasite type and location, but often include:
- Gastrointestinal issues: Diarrhea, abdominal pain, bloating, nausea, vomiting.
- Physical changes: Unexplained weight loss, loss of appetite, fatigue.
- Skin/Irritation: Itchy rashes, or symptoms related to specific areas (e.g., eye, brain, lungs).
- Systemic: Fever, muscle pain, and headache.
Main Types of Parasites
- Protozoa: Single-celled organisms that can multiply inside the body (e.g., Giardia, Cryptosporidium, Toxoplasma).
- Helminths: Multicellular worms, such as tapeworms, roundworms, and flukes, which reside in the intestines or other organs.
- Ectoparasites: Organisms that live on the skin, such as lice, mites, and ticks. Infectious Diseases and Epidemiology Online Network |
Causes and Spread
- Contaminated Food/Water: Ingesting water, produce, or undercooked meat contaminated with parasite eggs or cysts.
- Bug Bites: Insects (mosquitoes, flies) transmitting parasites (e.g., Malaria, Leishmaniasis).
- Hygiene/Contact: Poor sanitation, walking barefoot in contaminated soil, or person-to-person
Treatment and Prevention
- Treatment: Doctors use diagnostic tests (stool, blood, or imaging) to identify the parasite and prescribe antiparasitic medications, antibiotics, or, in complex cases, multiple, sometimes specialized, medications.
- Prevention: Thoroughly cooking meat, washing fruits/vegetables, practicing good hygiene (handwashing), and drinking only safe water are critical.
Some common examples in the U.S. include giardiasis, toxoplasmosis, and trichomoniasis.
Total Count of RBC, WBC and Platelet 01797522136
Skin diseases
Skin diseases comprise a wide range of conditions that clog, inflame, or irritate the skin, often causing rashes, itching, redness, or changes in texture. Common types include acne, eczema (dermatitis), psoriasis, rosacea, and infections like cellulitis or warts. Causes range from genetic factors, bacteria, and immune system issues to environmental triggers. Cleveland Clinic +4
Common Types of Skin Diseases
- Acne: Clogged follicles (pores) causing pimples, blackheads, and cysts.
- Eczema (Atopic Dermatitis): Dry, itchy, and inflamed patches of skin.
- Psoriasis: Chronic, autoimmune condition leading to thick, scaly, red patches.
- Rosacea: Chronic redness, thick skin, and pimples, commonly on the face.
- Skin Infections: Bacterial (cellulitis), viral (cold sores, shingles), or fungal (tinea) infections.
- Pigmentation Disorders: Vitiligo (loss of skin pigment).
- Skin Cancer: Uncontrolled growth of abnormal skin cells (e.g., basal cell carcinoma, melanoma).
Common Symptoms
- Itchy, dry, or painful skin.
- Rashes, red bumps, or blisters.
- Scaly or thick skin patches.
- Changes in skin color or texture.
Causes and Risk Factors
Skin diseases can be caused by bacteria, viruses, or fungi trapping in skin pores. Other causes include immune system dysfunction (autoimmune diseases), genetic predisposition, allergens, irritants.
Diagnosis
Doctors diagnose skin conditions through physical examination, skin biopsies, allergy patch tests, or skin
Management
Treatment varies by condition, including topical creams, antibiotics, light therapy, and lifestyle modifications to avoid triggers
Total Count of RBC, WBC and Platelet 01797522136
5. Basophils (0–1%)
Basophils are the least common type of white blood cell is produced in the bone marrow and responsible for mediating immune responses, particularly allergic reactions and parasitic infections. When activated, they release histamine (causing inflammation), heparin (preventing clotting), and cytokines to fight infections.
Total Count of RBC, WBC and Platelet 01797522136
Key Aspects of Basophils:
- Function: They are crucial in allergic reactions (e.g., asthma, dermatitis) and defense against parasites.
- Appearance: They are granulocytes with dark-staining, coarse grains in their cytoplasm.
- Activation: Activated by IgE-mediated reactions, pathogens, and complement factors.
- Normal Range: Usually
of white blood cells or
cells per microliter.
- Abnormal Levels:
- Basophilia (High Count): Indicates potential allergies, chronic inflammation, or blood diseases like chronic myeloid leukemia (CML).
- Basopenia (Low Count): Difficult to detect due to low normal levels but can occur with severe allergic reactions
Basophils are the least common type of WBC.
Functions:
- Release histamine
- Involvement in allergic reactions
- Regulation of inflammatory responses
Basophilia is rare but may occur in chronic myelogenous leukemia (CML) and allergic conditions.
Total Count of RBC, WBC and Platelet 01797522136
Normal WBC Count
The normal WBC count for adults typically ranges from:
4,000 to 11,000 cells per microliter of blood
This value may vary depending on health conditions and laboratory standards.
Total Count of RBC, WBC and Platelet 01797522136
Causes of High WBC Count
A high WBC count is called leukocytosis and may occur due to:
- Bacterial infections
- Inflammation
- Leukemia
- Physical stress
- Tissue injury
Total Count of RBC, WBC and Platelet 01797522136
Causes of Low WBC Count
A low WBC count is known as leukopenia and may be caused by:
- Viral infections
- Bone marrow disorders
- Chemotherapy
- Autoimmune diseases
- Severe infections
Total Count of RBC, WBC and Platelet 01797522136
What is Platelet Count?
Platelet count measures the number of platelets in the blood.
Platelets are essential for blood clotting and preventing excessive bleeding. They gather at injury sites and form clots to stop bleeding.
Normal Platelet Count
The normal platelet count ranges from:
150,000 to 450,000 platelets per microliter of blood
Total Count of RBC, WBC and Platelet 01797522136
Functions of Platelets
Platelets play several important roles in the body.
Blood Clot Formation
Platelets aggregate at the site of injury and form a clot to stop bleeding.
Wound Healing
Platelets release growth factors that promote tissue repair and healing.
Total Count of RBC, WBC and Platelet 01797522136
Causes of High Platelet Count
An elevated platelet count is called thrombocytosis.
Common causes include:
- Infections
- Iron deficiency
- Cancer
- Bone marrow disorders
- Inflammatory diseases
Causes of Low Platelet Count
A low platelet count is known as thrombocytopenia.
Common causes include:
- Dengue fever
- Viral infections
- Bone marrow diseases
- Certain medications
- Autoimmune disorders
Total Count of RBC, WBC and Platelet 01797522136
Methods of Counting RBC, WBC, and Platelets
Blood cell counting can be performed using two main methods.
Manual Method
The manual method uses a microscope and hemocytometer (Neubauer chamber).
Steps include:
- Blood sample collection with anticoagulant
- Dilution of blood with appropriate diluting fluid
- Loading the diluted sample into a hemocytometer
- Counting cells under a microscope
- Calculating the final cell count
This method is commonly used in laboratory training.
Total Count of RBC, WBC and Platelet 01797522136
Automated Hematology Analyzer
Modern laboratories often use automated hematology analyzers which provide fast and accurate results.
Advantages include:
- High accuracy
- Quick results
- Reduced human error
- Multiple parameters measured simultaneously
However, manual methods remain important for educational purposes.
Total Count of RBC, WBC and Platelet 01797522136
Laboratory Equipment Used for Blood Cell Counting
The following equipment is commonly used in hematology laboratories:
- Microscope
- Hemocytometer
- RBC pipette
- WBC pipette
- Test tubes
- Centrifuge
- Automated hematology analyzer
- Glass slides
Students must learn how to properly use these instruments.
Total Count of RBC, WBC and Platelet 01797522136
Importance of RBC, WBC, and Platelet Count in Diagnosis
Blood cell counts help doctors diagnose many diseases.
Detection of Anemia
Low RBC count helps identify anemia and its severity.
Detection of Infections
High WBC count often indicates infection or inflammation.
Detection of Blood Disorders
Abnormal counts may indicate leukemia or other blood diseases.
Monitoring Treatment
Doctors use these tests to monitor treatments such as chemotherapy or medications.
Total Count of RBC, WBC and Platelet 01797522136
Hematology Practical Training at HRTD Medical Institute
HRTD Medical Institute is dedicated to providing professional training in medical laboratory technology and pathology.
The institute focuses on practical learning and skill development.
Total Count of RBC, WBC and Platelet 01797522136
Key Features of Training
- Modern laboratory facilities
- Experienced instructors
- Hands-on training
- Clinical laboratory exposure
- Career-oriented courses
Students learn important laboratory procedures including:
- Total RBC count
- Total WBC count
- Platelet count
- Hemoglobin estimation
- Blood grouping
- Differential WBC count
- ESR test
This practical training prepares students for real laboratory work.
Total Count of RBC, WBC and Platelet 01797522136
Career Opportunities After Learning Hematology
Students trained in hematology and laboratory technology can pursue careers in:
- Hospitals
- Diagnostic laboratories
- Research laboratories
- Medical colleges
- Blood banks
- Public health laboratories
Common job roles include:
- Medical Laboratory Technologist
- Pathology Lab Technician
- Diagnostic Center Technician
- Research Laboratory Assistant
Graduates from HRTD Medical Institute gain the knowledge and skills required for these professions.
Total Count of RBC, WBC and Platelet 01797522136
Why Choose HRTD Medical Institute?
There are many reasons why students choose HRTD Medical Institute for pathology and laboratory training.
Practical Laboratory Training
Students gain hands-on experience in performing real diagnostic tests.
Experienced Faculty
Qualified instructors provide professional guidance and training.
Career-Focused Courses
Courses are designed to prepare students for employment in diagnostic laboratories.
Modern Equipment
Training is conducted using standard laboratory instruments.
Total Count of RBC, WBC and Platelet 01797522136
Future of Medical Laboratory Technology
The demand for skilled laboratory professionals is increasing worldwide. Accurate laboratory testing is essential for disease diagnosis and patient treatment.
With advancements in medical technology, laboratory professionals must continuously update their knowledge and skills.
Institutions like HRTD Medical Institute play an important role in preparing students for this growing healthcare field.
Total Count of RBC, WBC and Platelet 01797522136
Conclusion
The Total Count of RBC, WBC, and Platelets is a fundamental laboratory investigation used to assess a patient’s health. These tests help diagnose various medical conditions including anemia, infections, immune disorders, bleeding disorders, and blood cancers.
Understanding the principles, procedures, and clinical significance of these tests is essential for medical students and laboratory technologists.
Through its comprehensive training programs, HRTD Medical Institute provides students with the theoretical knowledge and practical laboratory skills needed to perform hematological tests accurately and confidently.
As healthcare continues to evolve, skilled laboratory professionals will remain essential for accurate diagnosis and effective patient care.
Total Count of RBC, WBC and Platelet 01797522136
Frequently Asked Questions (FAQs)
What is RBC, WBC, and Platelet count?
RBC, WBC, and platelet count refers to the measurement of red blood cells, white blood cells, and platelets in the blood. These counts help evaluate overall health and diagnose diseases.
Why is the RBC count important?
The RBC count helps determine the oxygen-carrying capacity of blood and is essential for diagnosing anemia and other blood disorders.
What happens if WBC count is high?
A high WBC count may indicate infection, inflammation, stress, or certain blood diseases.
What does a low platelet count mean?
A low platelet count may increase the risk of bleeding and may occur due to infections, bone marrow disorders, or autoimmune diseases.
Total Count of RBC, WBC and Platelet 01797522136
Where can students learn hematology laboratory techniques in Bangladesh?
Students can receive professional training in hematology and pathology at HRTD Medical Institute, which offers practical laboratory training and career-oriented courses.
 Pathology Training Institute in Bangladesh Best Pathology Training Institute in Bangladesh
Pathology Training Institute in Bangladesh Best Pathology Training Institute in Bangladesh